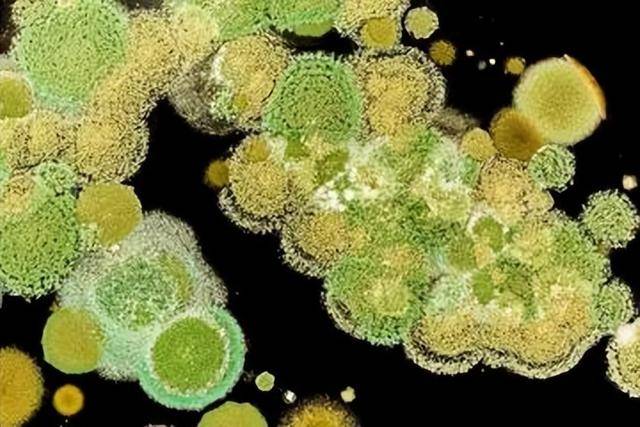

一说“致癌”,很多人第一反应就是咸菜、腊肉、烧烤,立刻把坛坛罐罐、烟熏火烤拉出来批判一通。
但说实话,真正吃得最多的早就不是这些“老派危险分子”,而是超市货架、外卖袋子和奶茶杯里那一套:看着方便、吃着上瘾、还经常被包装成“更健康”的工业食品。

以为躲开了亚硝酸盐就万事大吉?
真正的风险,可能就藏在每天顺手买的那一口里。下面这4样,才是更需要警惕的“常见坑”。

第1名:加工肉类,很多人每天都在吃,却不知是明确的一级致癌物。
这里说的加工肉类,不是家里自己做的腊肉,而是超市里卖的火腿、培根、香肠、肉罐头,还有平时吃的牛肉干、咸鱼等。

这些食物为了保鲜、上色,生产时会添加亚硝酸盐,这种物质进入人体后,会转化成亚硝胺,这是强致癌物质,长期大量摄入,会显著增加患结直肠癌的风险。
根据研究,每天吃50克加工肉类,患结直肠癌的风险就会增加18%,它的致癌风险和烟草、石棉被列在同一类别。

很多中老年人图方便,早上配粥吃火腿、培根,平时看电视吃牛肉干。
不知不觉就吃多了,长期下来,身体就会积累致癌隐患,这也是它能成为第1名的原因。

第2名:被黄曲霉毒素污染的食物,毒性极强,普通烹饪根本去不掉。
黄曲霉毒素是已知最强的化学致癌物之一,毒性是砒霜的68倍,长期接触会大大增加患肝癌的风险,被世界卫生组织列为一级致癌物。
这种毒素特别喜欢藏在发霉的食物里,比如放久了发霉的花生、玉米、大米,还有受潮变质的坚果、自榨油,甚至是发霉的茶叶、久泡变质的木耳。

很多中老年人过日子节俭,看到食物只是有点发霉,就觉得切掉发霉部分还能吃。
其实毒素早就扩散到整个食物里了,而且它极其耐高温,日常炒菜、煮粥的温度根本破坏不了它,吃一次就会给身体带来一次伤害。

第3名:高温油炸、烧烤类食物,香气背后藏着致癌隐患。
很多人喜欢吃炸薯条、炸鸡、油条,还有晚上约着吃烧烤,这些食物虽然好吃,但风险很大。

高温油炸或明火烧烤时,食物会产生苯并芘、丙烯酰胺等致癌物质,这些物质会在体内积累,长期大量摄入,会增加多种癌症的风险。
尤其是烧烤时烤焦的部分。

致癌物质含量会大幅升高,很多人觉得焦香好吃,特意吃烤焦的肉串,其实是在主动摄入致癌物。
另外,反复使用的煎炸油,会产生更多有毒物质,长期用这种油炒菜,同样会危害健康。

第4名:高糖饮料,喝着爽口,却在悄悄伤害身体。
现在不管是年轻人还是中老年人,都喜欢喝含糖饮料,比如可乐、果汁、奶茶等,很多人觉得喝这个能解渴、解腻,却不知道它的危害。

含糖饮料是人体摄入添加糖的主要来源,长期大量饮用,会导致体重增加,引发肥胖,而肥胖本身就是多种癌症的危险因素,还会增加患2型糖尿病、心脏病的风险,间接诱发癌症。
另外,有些含糖饮料中还含有多种食品添加剂,长期过量摄入,会加重肝脏、肾脏的代谢负担,累积下来也会增加健康风险。

很多中老年人觉得果汁是健康的,每天喝一杯,却不知道市售果汁大多添加了大量糖分,比可乐的危害不相上下。
很多人会有疑问,是不是吃了这些食物就一定会得癌症?

其实不是这样的,癌症的发生是长期、多种因素共同作用的结果,偶尔吃一次不会有太大问题,但长期大量摄入,就会让患癌风险大幅升高。
我们不用过度焦虑,也不用刻意戒掉所有食物,关键是学会控制摄入量。
相比于咸菜、腊肉这些不常吃的“老派危险分子”,上面这4样食物,才是我们日常接触最多、风险最高的。

尤其是第1名的加工肉类,很多人每天都在吃,却忽略了它的危害。
健康饮食没有捷径,远离这些常见的“致癌坑”,养成清淡、健康的饮食习惯,才能更好地守护自己和家人的身体健康,远离癌症的困扰。